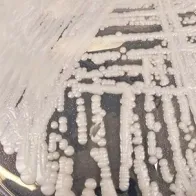
Candida Auris

Survey on the epidemiological situation, laboratory capacity and preparedness for Candidozyma (Candida) auris, 2024
Key findings
Candidozyma auris (formerly Candida auris) poses a risk for patients in healthcare facilities across Europe due to its ability to cause severe infections in critically ill patients, its potential resistance to several antifungal agents, which makes infections difficult to treat, and its propensity for transmission and outbreaks in healthcare settings. The C. auris survey 2024 shows that spread of C. auris continues to occur at a rapid pace. In total, 4 012 cases of C. auris colonisation or infection were reported by European Union (EU)/European Economic Area (EEA) countries between 2013 and 2023. The five countries with highest C. auris case numbers were Spain, Greece, Italy, Romania and Germany. Since 2020, case numbers have been increasing rapidly until 2023 when 1 346 yearly cases were reported by 18 EU/EEA countries. Despite this increase, the recorded case numbers only reflect the tip of the iceberg as systematic surveillance is not in place in many countries. While the previous three ECDC C. auris surveys were restricted to EU/EEA countries, the EU enlargement countries of the Western Balkans and Türkiye were also invited to participate in C. auris survey 2024. Türkiye, Kosovo1, and Bosnia and Herzegovina reported a total of 121 C. auris cases.
Recent distinct C. auris outbreaks were reported by three countries (Cyprus, France and Germany) while four countries (Greece, Italy, Romania and Spain) reported that it was no longer possible to distinguish specific outbreaks in a situation of regional endemicity. The period between a documented first case in the country and regional endemicity according to the ECDC staging system has been between five and seven years for Greece, Italy and Spain, showing how rapidly C. auris can spread through hospital networks. This rapid dissemination of C. auris is of serious concern and points to a high risk for continued C. auris spread throughout European healthcare systems. With increasing C. auris cases and its widespread geographic distribution, sustained control will become more difficult. The C. auris survey 2024 also showed that there were still gaps in national preparedness, especially regarding national surveillance systems and guidance for infection prevention and control (IPC) measures. National efforts for early detection, surveillance and rapid implementation of IPC measures to contain or delay further spread of C. auris can still mitigate its impact on hospitalised patients in Europe.
Survey on the epidemiological situation, laboratory capacity and preparedness for Candidozyma (Candida) auris, 2024
English (1.15 MB - PDF)Read the press release
The latest survey from ECDC, the fourth of its kind, confirms that Candidozyma auris (formerly Candida auris) continues to spread quickly across European hospitals.
Listen to the podcast

ECDC's Head of Section - Antimicrobial Resistance and Healthcare-Associated Infections -Diamantis Plachouras explains the rising threat of the drug-resistant fungus Candidozyma (Candida) auris.
Share this page
